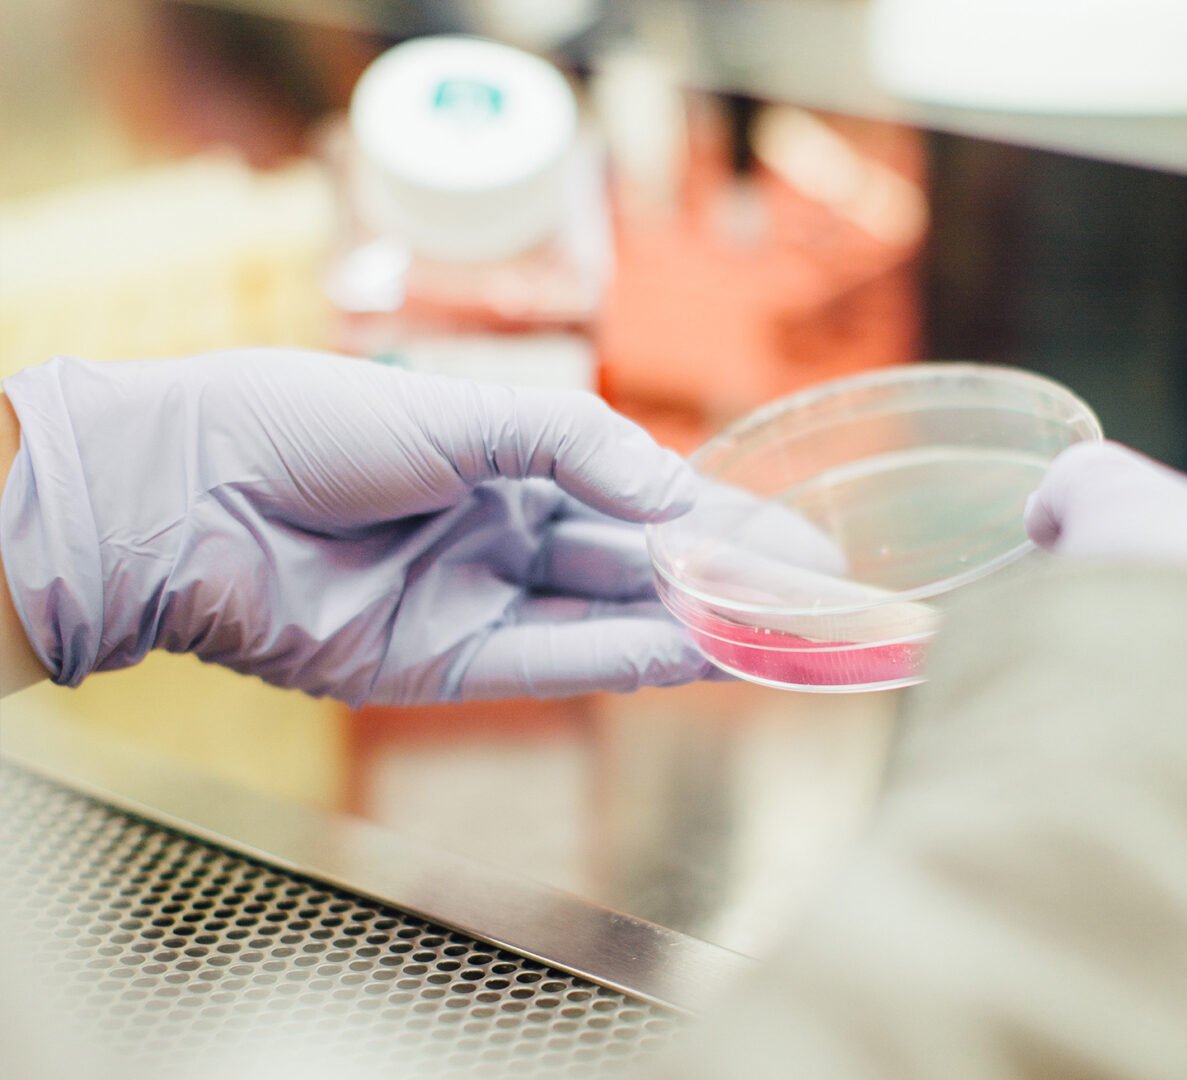

Acá comienza el camino
hacia tu Bienestar

NOSOTROS
Hace más de 30 años, los Dres. Sommariva, Gagliardo (padre) y Gianotti fundaron en Río Cuarto el primer centro especializado en procedimientos artroscópicos. Con el tiempo, se sumaron nuevos profesionales, consolidando un equipo enfocado en traumatología, ortopedia y artroscopia.
El crecimiento del centro permitió incorporar especialidades como cardiología, pediatría y clínica médica, junto a servicios de diagnóstico y tratamiento interdisciplinario: laboratorio, kinesiología y radiología digital.
Actualmente, desarrollamos el área de medicina bioregenerativa, un enfoque innovador orientado a mejorar los procesos de recuperación de articulaciones, músculos y tejidos.
Brindamos una atención médica integral, humana y personalizada, respaldada por más de tres décadas de experiencia.

MISIÓN
Brindar atención especializada en traumatología, ortopedia y artroscopia, orientada a la recuperación funcional del paciente, mediante profesionales altamente capacitados, tecnología de vanguardia y un enfoque integral centrado en la persona.
VISIÓN
Ser el centro de referencia en traumatología y artroscopia del centro del país, reconocido por su calidad médica, innovación tecnológica y resultados clínicos. Integrar diagnóstico por imágenes y tratamientos mínimamente invasivos para ofrecer soluciones precisas, seguras y de rápida recuperación.
ESPECIALIDADES
Y ESPECIALISTAS
Traumatología y Ortopedia
Traumatólogo y Ortopedista
M.P. 8508 - M.E. 2540
Traumatólogo y Ortopedista
M.P. 29015
Traumatólogo y Ortopedista
M.P. 33599 - M.E. 17297
Traumatólogo
M.P. 39118 - M.E. 20057
Medicina Regenerativa y terapia celular
Traumatólogo
M.P. 39118 - M.E. 20057
Traumatólogo y Ortopedista
M.P. 29015
Traumatólogo y Ortopedista
M.P. 8508 - M.E. 2540
Traumatólogo y Ortopedista
M.P. 33599 - M.E. 17297
Medicina del dolor
Anestesiólogo y Terapia del Dolor
M.P. 1479 - M.E. 6725
Clínica Médica
Médica Clínica
M.P. 30849 - M.E. 14807
Pediatría
Pediatra
M.P. 17220 - M.E. 7448
Cardiología
Esp. en Cardiología
M.P. 14152 - M.E. 3857
Alergia e Inmunología
Inmuno dermatología
M.P. 14151 - M.E. 9352
Radiología
Lic. en Producción de Bioimágenes
M.P. 100205-53
Kinesiología
Kinesióloga
M.P. 3632
Kinesióloga
M.P. 7460
Kinesiólogo
M.P. 8737
Kinesiólogo
M.P. 8737
Kinesióloga
M.P. 7069
Kinesióloga
M.P. 7306
Kinesiólogo
M.P. 8626
Kinesióloga
M.P. 8674
Laboratorio
Bioquímica
M.P. 3699
Bioquímica
M.P. 3818
Bioquímica
M.P. 3873
Ecografía general
Ecografía general
M.P. 39270 - M.E. 17990
Cirugía con internación de día
Anestesiólogo y Terapia del Dolor
M.P. 1479 - M.E. 6725
Traumatólogo y Ortopedista
M.P. 8508 - M.E. 2540
Traumatólogo y Ortopedista
M.P. 29015
Traumatólogo y Ortopedista
M.P. 33599 - M.E. 17297
Traumatólogo
M.P. 39118 - M.E. 20057
Enfermera profesional
Enfermera profesional
Administración
Secretaria
Secretaria
Secretaria
Secretaria
MEDICINA REGENERATIVA Y TERAPIA CELULAR
Medicina del futuro para los problemas del presente.
Técnicas médicas de avanzada para el tratamiento de diversas patologías. Plasma rico en plaquetas, plasma rico en plaquetas hiperconcentrado, Nanofat. Tratamientos que activan la propia biología del cuerpo para recuperar la salud.
DEPARTAMENTO DE CIRUGÍA
CIRUGÍA MÍNIMANENTE INVASIVA DE ARTICULACIONES
Cirugías traumatológicas con mínimas incisiones. Intervenciones en pies con técnica MIS (Minimal Incision Surgery).
Contamos con amplia experiencia en cirugía traumatológica por video artroscopía. Nuestro cuerpo profesional está especialmente capacitado en esta técnica quirúrgica, guiados por el Dr. Odone Sommariva, uno de los primeros artroscopistas de la provincia de Córdoba.
Nos especializamos en cirugía mínimamente invasiva de las articulaciones y del pie. Nuestra preparación, formación y práctica se orientan a este tipo de abordaje quirúrgico lo cual nos brinda un amplio conocimiento al respecto apuntalado por la importante cantidad de casos atendidos a diario.


RESPONDEMOS TUS CONSULTAS
¿Cuáles son nuestros horarios?
- Lunes a Jueves de 8 a 20 hs.
- Viernes de 8 a 16 hs.
- Sábados y Domingos cerrado.
¿Cómo reservo un turno?
Para solicitar un turno, encontrá en la web un botón en el menú o flotante ubicado abajo.
Al presionarlo, se abrirá el turnero y allí deberás realizar estos simples pasos:
1) Ingresar tu DNI.
2) Seleccionar el profesional.
3) Elegir el día y horario disponible.
Finalmente, confirmá el turno para completar la reserva.
¿QUÉ DICEN DE NOSOTROS?
UBICACIÓN
¿DÓNDE NOS ENCONTRÁS?
Buenos Aires 659
Río Cuarto, Córdoba, Argentina
- (0358) 46 37 011
- (0358) 46 47 100
- 358 422 1808

